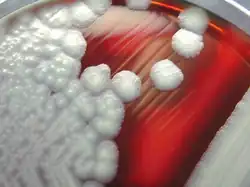
"B. cereus" colonies on a sheep-blood agar plate

Bacillus cereus
| Bacillus cereus | |
|---|---|
| |
| B. cereus colonies on a sheep blood agar plate | |
| Scientific classification | |
| Domain: | Bacteria |
| Kingdom: | Bacillati |
| Phylum: | Bacillota |
| Class: | Bacilli |
| Order: | Bacillales |
| Family: | Bacillaceae |
| Genus: | Bacillus |
| Species: | B. cereus
|
| Binomial name | |
| Bacillus cereus Frankland & Frankland 1887
| |
| Biovars | |

Bacillus cereus is a Gram-positive rod-shaped bacterium commonly found in soil, food, and marine sponges.[1] The specific name, cereus, meaning "waxy" in Latin, refers to the appearance of colonies grown on blood agar. Some strains are harmful to humans and cause foodborne illness due to their spore-forming nature, while other strains can be beneficial as probiotics for animals, and even exhibit mutualism with certain plants.[2][3][4] B. cereus bacteria may be aerobes or facultative anaerobes, and like other members of the genus Bacillus, can produce protective endospores. They have a wide range of virulence factors, including phospholipase C, cereulide, sphingomyelinase, metalloproteases, and cytotoxin K, many of which are regulated via quorum sensing.[5][6] B. cereus strains exhibit flagellar motility.[7]
The Bacillus cereus group comprises seven closely related species: B. cereus sensu stricto (referred to herein as B. cereus), B. anthracis, B. thuringiensis, B. mycoides, B. pseudomycoides, and B. cytotoxicus;[8] or as six species in a Bacillus cereus sensu lato: B. weihenstephanensis, B. mycoides, B. pseudomycoides, B. cereus, B. thuringiensis, and B. anthracis.[9] A phylogenomic analysis combined with average nucleotide identity (ANI) analysis revealed that the B. anthracis species also includes strains annotated as B. cereus and B. thuringiensis.[10]
History
Colonies of B. cereus were originally isolated by Percy F. Frankland from a gelatine plate left exposed to the air in a cow shed in 1887.[11] In the 2010s, examination of warning letters issued by the US Food and Drug Administration issued to pharmaceutical manufacturing facilities addressing facility microbial contamination revealed that the most common contaminant was B. cereus.[12]
Several new enzymes have been discovered in B. cereus, such as AlkC and AlkD, both of which are involved in DNA repair.[13]
Microbiology

B. cereus is a rod-shaped bacterium with a Gram-positive cell envelope. Depending on the strain, it may be aerobic or facultatively anaerobic. Most strains are mesophilic, having an optimal temperature between 25 °C and 37 °C, and neutralophilic, preferring neutral pH, but some have been found to grow in environments with much more extreme conditions.[14]
These bacteria are both spore-forming and biofilm-forming, presenting a large challenge to the food industry due to their contamination capability. Biofilms of B. cereus most commonly form on air-liquid interfaces or on hard surfaces such as glass. B. cereus display flagellar motility, which has been shown to aid in biofilm formation via an increased ability to reach surfaces suitable for biofilm formation, to spread the biofilm over a larger surface area, and to recruit planktonic, or single, free-living bacteria.[7] Biofilm formation may also occur while in spore form due to varying adhesion ability of spores.[15]
Their flagella are peritrichous, meaning there are many flagella located all around the cell body that can bundle together at a single location on the cell to propel it. This flagellar property also allows the cell to change directions of movement depending on where on the cell the flagellum filaments come together to generate movement.[15][16]
Some studies and observations have shown that silica particles the size of a few nanometers have been deposited in a spore coat layer in the extracytoplasmic region of the Bacillus cereus spore. The layer was first discovered by the use of scanning transmission electron microscopy (STEM), however the images taken did not have resolution high enough to determine the precise location of the silica. Some investigators hypothesize that the layer helps different spores from sticking together. It has also been shown to provide some resistance to acidic environments. The silica coat is related to the permeability of the spore's inner membrane. Strong mineral acids are able to break down spore permeability barriers and kill the spore. However, when the spore has a silica coating, it may reduce the permeability of the membrane and provide resistance to many acids.[17]
Metabolism
Bacillus cereus has mechanisms for both aerobic and anaerobic respiration, making it a facultative anaerobe.[18] Its aerobic pathway consists of three terminal oxidases: cytochrome aa3, cytochrome caa3, and cytochrome bd, the use of each dependent on the amount of oxygen present in the environment.[19] The B. cereus genome encodes genes for metabolic enzymes including NADH dehydrogenases, succinate dehydrogenase, complex III, and cytochrome c oxidase, as well as others. Bacillus cereus can metabolize several different compounds to create energy, including carbohydrates, proteins, peptides, and amino acids.[18]
The Embden-Meyerhof pathway is the predominant pathway used by Bacillus cereus to catabolize glucose at every stage of the cell's development, according to estimates of a radiorespirometric method of glucose catabolism. This is true at times of germinative phases, as well as sporogenic phases. At the filamentous, granular, forespore, and transitional stages, the Embden-Meyerhof pathway was responsible for the catabolism of 98% of the cell's glucose. The remainder of the glucose was catabolized by the hexose monophosphate oxidative pathway.[20]
Analysis of the core genome of B. cereus reveals a limited presence of enzymes meant for breakdown of polysaccharides and a prevalence of proteases and amino acid degradation and transport pathways, indicating that their preferred diet consists of proteins and their breakdown products.[21]
An isolate of a bacterium found to produce PHBs was identified as B. cereus through analysis of 16S rRNA sequences as well as similarity of morphological and biochemical characteristics. PHBs may be produced when there is excess carbon or limited essential nutrients present in the environment, and they are later broken down by the microbe as a fuel source under starvation conditions. This indicates the potential role of B. cereus in producing biodegradable plastic substitutes. PHB production was highest when provided with glucose as a carbon source.[22]
Genomics
The genome of B. cereus has been characterized and shown to contain over 5 million bp of DNA. Out of these, more than 5500 protein-encoding genes have been identified, of which the top categories of genes with known functions include: metabolic processes, processing of proteins, virulence factors, response to stress, and defense mechanisms. Many of the genes categorized as virulence factors, stress responses, and defense mechanisms encode factors in antibiotic resistance.[6] There are approximately 600 genes which are common in 99% of the taxa of B. cereus sensu lato, which constitutes around 1% of all genes in the pan-genome. Due to the prevalence of horizontal gene transfer among bacteria, the pan-genome of B. cereus is continually expanding.[23] The GC content of its DNA across all strains is approximately 35%.[24]
Following exposure to non-lethal acid shock at pH 5.4-5.5, the arginine deiminase gene in B. cereus, arcA, shows substantial up-regulation. This gene is part of the arcABC operon which is induced by low-pH environments in Listeria monocytogenes, and is associated with growth and survival in acidic environments. This suggests that this gene is also important for survival of B. cereus in acidic environments.[25]
The activation of virulence factors has been shown to be transcriptionally regulated via quorum-sensing in B. cereus. The activation of many virulence factors secreted is dependent on the activity of the Phospholipase C regulator (PlcR), a transcriptional regulator which is most active at the beginning of the stationary phase of growth. A small peptide called PapR acts as the effector in the quorum-sensing pathway, and when reimported into the cell, it interacts with PlcR to activate transcription of these virulence genes.[6] When point mutations were introduced into the plcR gene using the CRISPR/Cas9 system, it was observed that the mutated bacteria lost their hemolytic and phospholipase activity.[26]
The flagella of B. cereus are encoded by 2 to 5 fla genes, depending on the strain.[7]
Identification

For the isolation and enumeration of B. cereus, there are two standardized methods by International Organization for Standardization (ISO): ISO 7932 and ISO 21871. Because of B. cereus' ability to produce lecithinase and its inability to ferment mannitol, there are some proper selective media for its isolation and identification such as mannitol-egg yolk-polymyxin (MYP) and polymyxin-pyruvate-egg yolk-mannitol-bromothymol blue agar (PEMBA). B. cereus colonies on MYP have a violet-red background and are surrounded by a zone of egg-yolk precipitate.[27]
Below is a list of differential techniques and results that can help to identify B. cereus from other bacteria and Bacillus species.[28]
- Anaerobic growth: Positive
- Voges Proskauer test: Positive
- Acid produced from
- D-glucose: Positive
- L-arabinose: Negative
- D-xylose: Negative
- D-mannitol: Negative
- Starch hydrolysis: Positive
- Nitrate reduction: Positive
- Degradation of tyrosine: Positive
- Growth at
- above 50 °C: Negative
- Use of citrate: Positive
The Central Public Health Laboratory in the United Kingdom tests for motility, hemolysis, rhizoid growth, susceptibility to γ-phage, and fermentation of ammonium salt-based glucose but no mannitol, arabinose, or xylose.[27]
Growth
The optimal growth temperature range for B. cereus is 30-40 °C.[29] At 30 °C (86 °F), a population of B. cereus can double in as little as 20 minutes or as long as 3 hours, depending on the food product. Spores of B. cereus are not metabolically active, but can rapidly become active and begin replicating once they encounter adequate growth conditions.[30]
| Food | Minutes to double, 30 °C (86 °F) | Hours to multiply by 1,000,000 |
|---|---|---|
| Milk | 20–36 | 6.6 - 12 |
| Cooked rice | 26–31 | 8.6 - 10.3 |
| Infant formula | 56 | 18.6 |
Ecology
Like most Bacilli, the most common ecosystem of Bacillus cereus is the soil. In concert with arbuscular mycorrhiza (and Rhizobium leguminosarum in clover), they can up-regulate plant growth in heavy metal soils by decreasing heavy metal concentrations via bioaccumulation and biotransformation in addition to increasing phosphorus, nitrogen, and potassium uptake in certain plants.[4] B. cereus was also shown to aid in survival of earthworms in heavy metal soils resulting from the use of metal-based fungicides, showing increases in biomass, reproduction and reproductive viability, and a decrease in metal content of tissues in those inoculated with the bacterium.[31] These results suggest strong possibilities for its application in ecological bioremediation. Evidence of bioremediation potential by Bacillus cereus was also found in the aquatic ecosystem, where organic nitrogen and phosphorus wastes polluting a eutrophic lake were broken down in the presence of B. cereus.[29]
In a study measuring the ability of B. cereus to degrade keratin in chicken feathers, bacteria were found to sufficiently biodegrade keratin via hydrolytic mechanisms. These results indicate its potential to degrade keratinous waste from the poultry industry for potential recycling of the byproducts.[32]
B. cereus competes with Gram-negative bacteria species such as Salmonella and Campylobacter in the gut; its presence reduces the number of Gram-negative bacteria, specifically via antibiotic activity via enzymes such as cereins that impede their quorum sensing ability and exhibit bactericidal activity.[33][34] In food animals such as chickens,[35] rabbits[36] and pigs,[37] some harmless strains of B. cereus are used as a probiotic feed additive to reduce Salmonella in the animals' intestines and cecum. This improves the animals' growth, as well as food safety for humans who eat them. In addition, B. cereus create and release enzymes that aid in the digestion of materials that are typically difficult to digest, such as woody plant matter, in the guts of other organisms.[33]
The strain B. cereus B25 is a biofungicide.[38] A study by Figueroa-López et al. showed that the presence of this strain reduced Fusarium verticillioides growth.[38] B25 shows promise for reduction of mycotoxin concentrations in grains.[38]
Pathogenesis
B. cereus is responsible for a minority of foodborne illnesses (2–5%), causing severe nausea, vomiting, and diarrhea.[39] Bacillus foodborne illnesses occur due to survival of the bacterial endospores when contaminated food is not, or is inadequately, cooked.[40] Cooking temperatures less than or equal to 100 °C (212 °F) allow some B. cereus spores to survive.[41] This problem is compounded when food is then improperly refrigerated, allowing the endospores to germinate.[42] Cooked foods not meant for either immediate consumption or rapid cooling and refrigeration should be kept at temperatures below 10 °C (50 °F) or above 50 °C (122 °F).[41] Germination and growth generally occur between 10 °C and 50 °C,[41] though some strains can grow at low temperatures,[43] and Bacillus cytotoxicus strains have been shown to grow at temperatures up to 52 °C (126 °F).[44] Bacterial growth results in production of enterotoxins, one of which is highly resistant to heat and acids (pH levels between 2 and 11);[45] ingestion leads to two types of illness: diarrheal and emetic (vomiting) syndrome.[46] The enterotoxins produced by B. cereus have beta-hemolytic activity.[14]
- The diarrheal type is associated with a wide range of foods, has an 8-to-16-hour incubation time, and is associated with diarrhea and gastrointestinal pain. Also known as the 'long-incubation' form of B. cereus food poisoning, it might be difficult to differentiate from poisoning caused by Clostridium perfringens.[45] Enterotoxin can be inactivated after heating at 56 °C (133 °F) for 5 minutes, but whether its presence in food causes the symptom is unclear, since it degrades in stomach enzymes; its subsequent production by surviving B. cereus spores within the small intestine may be the cause of illness.[47]
- The 'emetic' form commonly results from rice which is cooked at a time and temperature insufficient to kill any spores present, then improperly refrigerated. The remaining spores can produce a toxin, cereulide, which is not inactivated by later reheating. This form leads to nausea and vomiting 1–5 hours after consumption. Distinguishing from other short-term bacterial foodborne intoxications, such as by Staphylococcus aureus, can be difficult.[45] Emetic toxin can withstand 121 °C (250 °F) for 90 minutes.[47] As a result of the emetic type's association with rice, it is sometimes referred to colloquially as fried rice syndrome.[48][49][50]
The diarrhetic syndromes observed in patients are thought to stem from the three toxins: hemolysin BL (Hbl), nonhemolytic enterotoxin (Nhe), and cytotoxin K (CytK).[51] The nhe/hbl/cytK genes are located on the chromosome of the bacteria. Transcription of these genes is controlled by PlcR. These genes occur in the taxonomically related B. thuringiensis and B. anthracis, as well. These enterotoxins are all produced in the small intestine of the host, thus thwarting digestion by host endogenous enzymes. The Hbl and Nhe toxins are pore-forming toxins closely related to ClyA of E. coli. The proteins exhibit a conformation known as a "beta-barrel" that can insert into cellular membranes due to a hydrophobic exterior, thus creating pores with hydrophilic interiors. The effect is loss of cellular membrane potential and eventually cell death.
Previously, it was thought that the timing of the toxin production was responsible for the two different courses of disease, but it has since been found that the emetic syndrome is caused by the toxin cereulide, which is found only in emetic strains and is not part of the "standard toolbox" of B. cereus. Cereulide is a cyclic polypeptide containing three repeats of four amino acids: D-oxy-Leu—D-Ala—L-oxy-Val—L-Val (similar to valinomycin produced by Streptomyces griseus) produced by nonribosomal peptide synthesis. Cereulide is believed to bind to 5-hydroxytryptamine 3 (5-HT3) serotonin receptors, activating them and leading to increased afferent vagus nerve stimulation.[52] It was shown independently by two research groups to be encoded on multiple plasmids: pCERE01[53] or pBCE4810.[54] Plasmid pBCE4810 shares homology with the B. anthracis virulence plasmid pXO1, which encodes the anthrax toxin. Periodontal isolates of B. cereus also possess distinct pXO1-like plasmids. Like most of cyclic peptides containing nonproteogenic amino acids, cereulide is resistant to heat, proteolysis, and acid conditions.[55]
B. cereus is also known to cause difficult-to-eradicate chronic skin infections, though less aggressive than necrotizing fasciitis. B. cereus can also cause keratitis.[56]
While often associated with gastrointestinal illness, B. cereus is also associated with illnesses such as fulminant bacterial infection, central nervous system involvement, respiratory tract infection, and endophthalmitis. Endophthalmitis is the most common form of extra-gastrointestinal pathogenesis, which is an infection of the eye that may cause permanent vision loss. Infections typically cause a corneal ring abscess, followed by other symptoms such as pain, proptosis, and retinal hemorrhage.[57] While different from B. anthracis, B. cereus contains some toxin genes originally found in B. anthracis that are attributed to anthrax-like respiratory tract infections.[58]
A case study was published in 2019 of a catheter-related bloodstream infection of B. cereus in a 91-year-old male previously being treated with hemodialysis via PermCath for end-stage renal disease. He presented with chills, tachypnea, and high-grade fever, his white blood cell count and high-sensitivity C-reactive protein (CRP) were significantly elevated, and CT imaging revealed a thoracic aortic aneurysm. He was successfully treated for the aneurysm with intravenous vancomycin, oral fluoroquinolones, and PermCath removal.[59] Another case study of B. cereus infection was published in 2021 of a 30-year-old woman with lupus who was diagnosed with infective endocarditis after receiving a catheter. The blood samples were positive for B. cereus and the patient was subsequently treated with vancomycin. PCR was also used to verify toxins that the isolate produces.[60]
Diagnosis
In case of foodborne illness, the diagnosis of B. cereus can be confirmed by the isolation of more than 100,000 B. cereus organisms per gram from epidemiologically implicated food, but such testing is often not done because the illness is relatively harmless and usually self-limiting.[61]
Prognosis
Most emetic patients recover within 6 to 24 hours,[46] but in some cases, the toxin can be fatal via fulminant hepatic failure.[62][63][64][65][66] In 2014, 23 newborns in the UK receiving total parenteral nutrition contaminated with B. cereus developed sepsis, with three of the infants later dying as a result of infection.[67][68]
Prevention
While B. cereus vegetative cells are killed during normal cooking, spores are more resistant. Viable spores in food can become vegetative cells in the intestines and produce a range of diarrheal enterotoxins, so elimination of spores is desirable. In wet heat (poaching, simmering, boiling, braising, stewing, pot roasting, steaming), spores require more than 5 minutes at 121 °C (250 °F) at the coldest spot to be destroyed. In dry heat (grilling, broiling, baking, roasting, searing, sautéing), 120 °C (248 °F) for 1 hour kills all spores on the exposed surface.[69] This process of eliminating spores is very important, as spores of B. cereus are particularly resistant, even after pasteurization or exposure to gamma rays.[24]
B. cereus and other members of Bacillus are not easily killed by alcohol; they have been known to colonize distilled liquors and alcohol-soaked swabs and pads in numbers sufficient to cause infection.[70][71]
A study of an isolate of Bacillus cereus that was isolated from the stomach of a sheep was shown to be able to break down β-cypermethrin (β-CY) which has been known to be an antimicrobial agent. This strain, known as GW-01, can break down β-CY at a significant rate when the bacterial cells are in high concentrations relative to the antimicrobial agent. It has also been noted that the ability to break down β-CY is inducible. However, as the concentration of β-CY increases, the rate of β-CY degradation decreases. This suggests that the agent also functions as a toxin against the GW-01 strain. This is significant as it shows that in the right concentrations, β-CY can be used as an antimicrobial agent against Bacillus cereus.[72]
Diseases in aquatic animals
Bacillus cereus group bacteria, notably B. cereus and B. thuringiensis, are also pathogenic to multiple aquatic organisms including Chinese softshell turtle (Pelodiscus sinensis), causing infection characterized by gross lesions such as hepatic congestion and enlarged spleen with high mortality.[73]
Bacteriophages
Bacteria of the B. cereus group are infected by bacteriophages belonging to the family Tectiviridae. This family includes tailless phages that have a lipid membrane or vesicle beneath the icosahedral protein shell and that are formed of approximately equal amounts of virus-encoded proteins and lipids derived from the host cell's plasma membrane. Upon infection, the lipid membrane becomes a tail-like structure used in genome delivery. The genome is composed of about 15-kilobase, linear, double-stranded DNA (dsDNA) with long, inverted terminal-repeat sequences (100 base pairs). GIL01, Bam35, GIL16, AP50, and Wip1 are examples of temperate tectiviruses infecting the B. cereus group.[74] Bacteriophage PBC1 is an exampled of a tailed virus that infects B. cereus.[75]
See also
References
- ^ Paul SI, Rahman MM, Salam MA, Khan MA, Islam MT (15 December 2021). "Identification of marine sponge-associated bacteria of the Saint Martin's island of the Bay of Bengal emphasizing on the prevention of motile Aeromonas septicemia in Labeo rohita". Aquaculture. 545: 737156. doi:10.1016/j.aquaculture.2021.737156.
- ^ Ryan KJ, Ray CG, eds. (2004). Sherris Medical Microbiology (4th ed.). McGraw Hill. ISBN 978-0-8385-8529-0.
- ^ Felis GE, Dellaglio F, Torriani S (2009). "Taxonomy of probiotic microorganisms". In Charalampopoulos D, Rastall RA (eds.). Prebiotics and Probiotics Science and Technology. Springer Science & Business Media. p. 627. ISBN 978-0-387-79057-2.
- ^ a b Azcón R, Perálvarez M, Roldán A, Barea JM (May 2010). "Arbuscular mycorrhizal fungi, Bacillus cereus, and Candida parapsilosis from a multicontaminated soil alleviate metal toxicity in plants". Microbial Ecology. 59 (4): 668–677. doi:10.1007/s00248-009-9618-5. PMID 20013261. S2CID 12075701.
- ^ Enosi Tuipulotu D, Mathur A, Ngo C, Man SM (May 2021). "Bacillus cereus: Epidemiology, Virulence Factors, and Host-Pathogen Interactions". Trends in Microbiology. 29 (5): 458–471. doi:10.1016/j.tim.2020.09.003. hdl:1885/219768. PMID 33004259. S2CID 222156441.
- ^ a b c Yossa N, Bell R, Tallent S, Brown E, Binet R, Hammack T (October 2022). "Genomic characterization of Bacillus cereus sensu stricto 3A ES isolated from eye shadow cosmetic products". BMC Microbiology. 22 (1): 240. doi:10.1186/s12866-022-02652-5. PMC 9533521. PMID 36199032.
- ^ a b c Houry A, Briandet R, Aymerich S, Gohar M (April 2010). "Involvement of motility and flagella in Bacillus cereus biofilm formation". Microbiology. 156 (Pt 4): 1009–1018. doi:10.1099/mic.0.034827-0. PMID 20035003.
- ^ Guinebretière MH, Auger S, Galleron N, Contzen M, De Sarrau B, De Buyser ML, et al. (January 2013). "Bacillus cytotoxicus sp. nov. is a novel thermotolerant species of the Bacillus cereus group occasionally associated with food poisoning". International Journal of Systematic and Evolutionary Microbiology. 63 (Pt 1): 31–40. doi:10.1099/ijs.0.030627-0. PMID 22328607. S2CID 2407509.
- ^ Kolstø AB, Tourasse NJ, Økstad OA (2009). "What sets Bacillus anthracis apart from other Bacillus species?". Annual Review of Microbiology. 63 (1). Annual Reviews: 451–476. doi:10.1146/annurev.micro.091208.073255. PMID 19514852.
- ^ Nikolaidis M, Hesketh A, Mossialos D, Iliopoulos I, Oliver SG, Amoutzias GD (August 2022). "A Comparative Analysis of the Core Proteomes within and among the Bacillus subtilis and Bacillus cereus Evolutionary Groups Reveals the Patterns of Lineage- and Species-Specific Adaptations". Microorganisms. 10 (9): 1720. doi:10.3390/microorganisms10091720. PMC 9505155. PMID 36144322.
- ^ Frankland GC, Frankland PF (1 January 1887). "Studies on some new micro-organisms obtained from air". Philosophical Transactions of the Royal Society B: Biological Sciences. 178: 257–287. Bibcode:1887RSPTB.178..257F. doi:10.1098/rstb.1887.0011. JSTOR 91702.
- ^ Sandle T (28 November 2014). "The risk of Bacillus cereus to pharmaceutical manufacturing". American Pharmaceutical Review (Paper). 17 (6): 56. Archived from the original on 25 April 2015.
- ^ Alseth I, Rognes T, Lindbäck T, Solberg I, Robertsen K, Kristiansen KI, et al. (March 2006). "A new protein superfamily includes two novel 3-methyladenine DNA glycosylases from Bacillus cereus, AlkC and AlkD". Molecular Microbiology. 59 (5): 1602–1609. doi:10.1111/j.1365-2958.2006.05044.x. PMC 1413580. PMID 16468998.
- ^ a b Drobniewski F (October 1993). "Bacillus cereus and Related Species". American Society for Microbiology. 6 (4): 324–338. doi:10.1128/CMR.6.4.324. PMC 358292. PMID 8269390.
- ^ a b Vilas-Bôas GT, Peruca AP, Arantes OM (June 2007). "Biology and taxonomy of Bacillus cereus, Bacillus anthracis, and Bacillus thuringiensis". Canadian Journal of Microbiology. 53 (6): 673–687. doi:10.1139/W07-029. PMID 17668027.
- ^ Riley EE, Das D, Lauga E (July 2018). "Swimming of peritrichous bacteria is enabled by an elastohydrodynamic instability". Scientific Reports. 8 (1): 10728. arXiv:1806.01902. Bibcode:2018NatSR...810728R. doi:10.1038/s41598-018-28319-8. PMC 6048115. PMID 30013040.
- ^ Hirota, Ryuichi; Hata, Yumehiro; Ikeda, Takeshi; Ishida, Takenori; Kuroda, Akio (January 2010). "The Silicon Layer Supports Acid Resistance of Bacillus cereus Spores". Journal of Bacteriology. 192 (1): 111–116. doi:10.1128/JB.00954-09. ISSN 0021-9193. PMC 2798246. PMID 19880606.
- ^ a b "Bacillus cereus - microbewiki". microbewiki.kenyon.edu. Retrieved 16 November 2022.
- ^ Chateau, Alice; Alpha-Bazin, Béatrice; Armengaud, Jean; Duport, Catherine (18 January 2022). "Heme A Synthase Deficiency Affects the Ability of Bacillus cereus to Adapt to a Nutrient-Limited Environment". International Journal of Molecular Sciences. 23 (3): 1033. doi:10.3390/ijms23031033. ISSN 1422-0067. PMC 8835132. PMID 35162964.
- ^ Goldman, Manuel; Blumenthal, Harold J. (February 1964). "Pathways of Glucose Catabolism in Bacillus Cereus". Journal of Bacteriology. 87 (2): 377–386. doi:10.1128/jb.87.2.377-386.1964. ISSN 0021-9193. PMC 277019. PMID 14151060.
- ^ Ivanova N, Sorokin A, Anderson I, Galleron N, Candelon B, Kapatral V, et al. (May 2003). "Genome sequence of Bacillus cereus and comparative analysis with Bacillus anthracis". Nature. 423 (6935): 87–91. Bibcode:2003Natur.423...87I. doi:10.1038/nature01582. PMID 12721630. S2CID 4361366.
- ^ Hamdy SM, Danial AW, Gad El-Rab SM, Shoreit AA, Hesham AE (July 2022). "Production and optimization of bioplastic (Polyhydroxybutyrate) from Bacillus cereus strain SH-02 using response surface methodology". BMC Microbiology. 22 (1): 183. doi:10.1186/s12866-022-02593-z. PMC 9306189. PMID 35869433.
- ^ Bazinet AL (August 2017). "Pan-genome and phylogeny of Bacillus cereus sensu lato". BMC Evolutionary Biology. 17 (1): 176. doi:10.1186/s12862-017-1020-1. PMC 5541404. PMID 28768476.
- ^ a b Chang T, Rosch JW, Gu Z, Hakim H, Hewitt C, Gaur A, et al. (February 2018). Freitag NE (ed.). "Whole-Genome Characterization of Bacillus cereus Associated with Specific Disease Manifestations". Infection and Immunity. 86 (2): e00574–17. doi:10.1128/IAI.00574-17. PMC 5778371. PMID 29158433.
- ^ Duport C, Jobin M, Schmitt P (4 October 2016). "Adaptation in Bacillus cereus: From Stress to Disease". Frontiers in Microbiology. 7: 1550. doi:10.3389/fmicb.2016.01550. PMC 5047918. PMID 27757102.
- ^ Wang Y, Wang D, Wang X, Tao H, Feng E, Zhu L, et al. (2019). "Highly Efficient Genome Engineering in Bacillus anthracis and Bacillus cereus Using the CRISPR/Cas9 System". Frontiers in Microbiology. 10: 1932. doi:10.3389/fmicb.2019.01932. PMC 6736576. PMID 31551942.
- ^ a b Griffiths D, Schraft H (2017). "Bacillus cereus food poisoning". In Dodd CE, Aldsworth T, Stein RA, Cliver DO, Riemann HP (eds.). Foodborne Diseases (3rd ed.). Elsevier. pp. 395–405. doi:10.1016/b978-0-12-385007-2.00020-6. ISBN 978-0-12-385007-2.
- ^ Harwood CR, ed. (1989). Bacillus. Springer Science. pp. 44–46. ISBN 978-1-4899-3502-1. OCLC 913804139.
- ^ a b Karim MA, Akhter N, Hoque S (2013). "Proteolytic activity, growth and nutrient release by Bacillus cereus LW-17". Bangladesh Journal of Botany. 42 (2): 349–353. doi:10.3329/bjb.v42i2.18043. ISSN 2079-9926.
- ^ Mikkola R (2006). Food and indoor air isolated Bacillus non-protein toxins: structures, physico-chemical properties and mechanisms of effects on eukaryotic cells (PDF) (Thesis). University of Helsinki. p. 12. ISBN 952-10-3549-8. Archived (PDF) from the original on 9 July 2019. Retrieved 24 October 2015.
- ^ Oladipo OG, Burt AF, Maboeta MS (January 2019). "Effect of Bacillus cereus on the ecotoxicity of metal-based fungicide spiked soils: Earthworm bioassay". Ecotoxicology. 28 (1): 37–47. doi:10.1007/s10646-018-1997-2. PMID 30430303. S2CID 53440898.
- ^ "Keratinolytic Potential of Feather-Degrading Bacillus polymyxa and Bacillus cereus". Polish Journal of Environmental Studies. 19 (2): 371–378. ISSN 1230-1485.
- ^ a b Swiecicka I (January 2008). "Natural occurrence of Bacillus thuringiensis and Bacillus cereus in eukaryotic organisms: a case for symbiosis". Biocontrol Science and Technology. 18 (3): 221–239. doi:10.1080/09583150801942334. ISSN 0958-3157. S2CID 85570720.
- ^ Naclerio G, Ricca E, Sacco M, De Felice M (December 1993). "Antimicrobial activity of a newly identified bacteriocin of Bacillus cereus". Applied and Environmental Microbiology. 59 (12): 4313–4316. Bibcode:1993ApEnM..59.4313N. doi:10.1128/AEM.59.12.4313-4316.1993. PMC 195902. PMID 8285719.
- ^ Vilà B, Fontgibell A, Badiola I, Esteve-Garcia E, Jiménez G, Castillo M, Brufau J (May 2009). "Reduction of Salmonella enterica var. Enteritidis colonization and invasion by Bacillus cereus var. toyoi inclusion in poultry feeds". Poultry Science. 88 (5): 975–979. doi:10.3382/ps.2008-00483. PMID 19359685.
- ^ Bories G, Brantom P, de Barberà JB, Chesson A, Cocconcelli PS, Debski B, et al. (9 December 2008). "Safety and efficacy of the product Toyocerin (Bacillus cereus var. toyoi) as feed additive for rabbit breeding does". EFSA Journal. Scientific Opinion of the Panel on Additives and Products or Substances used in Animal Feed. 2009 (1): 913. doi:10.2903/j.efsa.2009.913. eISSN 1831-4732. EFSA-Q-2008-287. Retrieved 14 May 2009.
- ^ Bories G, Brantom P, de Barberà JB, Chesson A, Cocconcelli PS, Debski B, et al. (16 March 2007). "Opinion of the Scientific Panel on Additives and Products or Substances used in Animal Feed on the safety and efficacy of the product Toyocerin (Bacillus cereus var. Toyoi) as a feed additive for sows from service to weaning, in accordance with Regulation (EC) No 1831/2003". EFSA Journal. Scientific Opinion of the Panel on Additives and Products or Substances used in Animal Feed. 2007 (3): 458. doi:10.2903/j.efsa.2007.458. eISSN 1831-4732. EFSA-Q-2006-037. Retrieved 14 May 2009.
- ^ a b c
- Verma M, Mishra J, Arora NK (2019). "Plant Growth-Promoting Rhizobacteria: Diversity and Applications". In Sobti RC, Arora NK, Kothari R (eds.). Environmental Biotechnology: For Sustainable Future. Springer Singapore. pp. 129–173. doi:10.1007/978-981-10-7284-0_6. ISBN 978-981-10-7283-3. S2CID 91258998.
- Ndemera M, De Boevre M, De Saeger S (2020). "Mycotoxin management in a developing country context: A critical review of strategies aimed at decreasing dietary exposure to mycotoxins in Zimbabwe". Critical Reviews in Food Science and Nutrition. 60 (4). Taylor & Francis: 529–540. doi:10.1080/10408398.2018.1543252. PMID 30501517. S2CID 54523328.
- Verma RK, Sachan M, Vishwakarma K, Upadhyay N, Mishra RK, Tripathi DK, Sharma S (2018). "Role of PGPR in Sustainable Agriculture: Molecular Approach Toward Disease Suppression and Growth Promotion". Role of Rhizospheric Microbes in Soil. Singapore: Springer Singapore. pp. 259–290. doi:10.1007/978-981-13-0044-8_9. ISBN 978-981-13-0043-1. S2CID 90538241.
- Shahid M, Zaidi A, Khan MS, Rizvi A, Saif S, Ahmed B (2017). "Recent Advances in Management Strategies of Vegetable Diseases". Microbial Strategies for Vegetable Production. Cham, Switzerland: Springer International Publishing. pp. 197–226. doi:10.1007/978-3-319-54401-4_9. ISBN 978-3-319-54400-7. S2CID 91152604.
- Figueroa-López AM, Cordero-Ramírez JD, Martínez-Álvarez JC, López-Meyer M, Lizárraga-Sánchez GJ, Félix-Gastélum R, et al. (2016). "Rhizospheric bacteria of maize with potential for biocontrol of Fusarium verticillioides". SpringerPlus. 5 (330): 330. doi:10.1186/s40064-016-1780-x. PMC 4792820. PMID 27066355. S2CID 12268357.
- ^ Kotiranta A, Lounatmaa K, Haapasalo M (February 2000). "Epidemiology and pathogenesis of Bacillus cereus infections". Microbes and Infection. 2 (2): 189–198. doi:10.1016/S1286-4579(00)00269-0. PMID 10742691.
- ^ Turnbull PC (1996). "Bacillus". In Baron S, et al. (eds.). Baron's Medical Microbiology (4th ed.). University of Texas Medical Branch. ISBN 978-0-9631172-1-2. PMID 21413260 – via NCBI Bookshelf.
- ^ a b c Roberts TA, Baird-Parker AC, Tompkin RB (1996). Characteristics of Microbial Pathogens. London: Blackie Academic & Professional. p. 24. ISBN 978-0-412-47350-0. Retrieved 25 November 2010.
- ^ McKillip JL (May 2000). "Prevalence and expression of enterotoxins in Bacillus cereus and other Bacillus spp., a literature review". Antonie van Leeuwenhoek. 77 (4): 393–399. doi:10.1023/A:1002706906154. PMID 10959569. S2CID 8362130.
- ^ Lawley R, Curtis L, Davis J (2008). The Food Safety Hazard Guidebook. Cambridge, UK: Royal Society of Chemistry. p. 17. ISBN 978-0-85404-460-3. Retrieved 25 November 2010.
- ^ Cairo J, Gherman I, Day A, Cook PE (January 2022). "Bacillus cytotoxicus-A potentially virulent food-associated microbe". Journal of Applied Microbiology. 132 (1): 31–40. doi:10.1111/jam.15214. PMC 9291862. PMID 34260791. S2CID 235906633.
- ^ a b c Todar K. "Bacillus cereus". Todar's Online Textbook of Bacteriology. Retrieved 19 September 2009.
- ^ a b Ehling-Schulz M, Fricker M, Scherer S (December 2004). "Bacillus cereus, the causative agent of an emetic type of food-borne illness". Molecular Nutrition & Food Research. 48 (7): 479–487. doi:10.1002/mnfr.200400055. PMID 15538709.
- ^ a b Millar I, Gray D, Kay H (1998). "Bacterial toxins found in foods". In Watson DH (ed.). Natural Toxicants in Food. CRC Press. pp. 133–134. ISBN 978-0-8493-9734-9.
- ^ Ross, Rachel (1 May 2019). "Bacillus Cereus: The Bacterium That Causes 'Fried Rice Sydrome'". livescience.com. Retrieved 19 August 2023.
- ^ Pelegrino, Elton N. (10 September 2021). "Fried Rice Syndrome: A common cause of food poisoning". www.nnc.gov.ph. Retrieved 19 August 2023.
- ^ "SFA | Fried Rice Syndrome". www.sfa.gov.sg. Retrieved 19 August 2023.
- ^ Guinebretière MH, Broussolle V, Nguyen-The C (August 2002). "Enterotoxigenic profiles of food-poisoning and food-borne Bacillus cereus strains". Journal of Clinical Microbiology. 40 (8): 3053–3056. doi:10.1128/JCM.40.8.3053-3056.2002. PMC 120679. PMID 12149378.
- ^ Agata N, Ohta M, Mori M, Isobe M (June 1995). "A novel dodecadepsipeptide, cereulide, is an emetic toxin of Bacillus cereus". FEMS Microbiology Letters. 129 (1): 17–20. doi:10.1016/0378-1097(95)00119-P. PMID 7781985.
- ^ Hoton FM, Andrup L, Swiecicka I, Mahillon J (July 2005). "The cereulide genetic determinants of emetic Bacillus cereus are plasmid-borne". Microbiology. 151 (Pt 7): 2121–2124. doi:10.1099/mic.0.28069-0. PMID 16000702.
- ^ Ehling-Schulz M, Fricker M, Grallert H, Rieck P, Wagner M, Scherer S (March 2006). "Cereulide synthetase gene cluster from emetic Bacillus cereus: structure and location on a mega virulence plasmid related to Bacillus anthracis toxin plasmid pXO1". BMC Microbiology. 6: 20. doi:10.1186/1471-2180-6-20. PMC 1459170. PMID 16512902.
- ^ Stenfors Arnesen LP, Fagerlund A, Granum PE (July 2008). "From soil to gut: Bacillus cereus and its food poisoning toxins". FEMS Microbiology Reviews. 32 (4): 579–606. doi:10.1111/j.1574-6976.2008.00112.x. PMID 18422617.
- ^ Pinna A, Sechi LA, Zanetti S, Usai D, Delogu G, Cappuccinelli P, Carta F (October 2001). "Bacillus cereus keratitis associated with contact lens wear". Ophthalmology. 108 (10): 1830–1834. doi:10.1016/S0161-6420(01)00723-0. PMID 11581057.
- ^ McDowell RH, Sands EM, Friedman H (12 September 2022). "Bacillus Cereus". PMID 29083665. Retrieved 27 October 2022.
- ^ Bottone EJ (April 2010). "Bacillus cereus, a volatile human pathogen". Clinical Microbiology Reviews. 23 (2): 382–398. doi:10.1128/CMR.00073-09. PMC 2863360. PMID 20375358.
- ^ Wu TC, Pai CC, Huang PW, Tung CB (November 2019). "Infected aneurysm of the thoracic aorta probably caused by Bacillus cereus: a case report". BMC Infectious Diseases. 19 (1): 959. doi:10.1186/s12879-019-4602-2. PMC 6849281. PMID 31711418.
- ^ Ribeiro RL, Bastos MO, Blanz AM, Rocha JA, Velasco NA, Marre AT, et al. (April 2022). "Subacute infective endocarditis caused by Bacillus cereus in a patient with Systemic Lupus Erythematosus". Journal of Infection in Developing Countries. 16 (4): 733–736. doi:10.3855/jidc.15685. PMID 35544639. S2CID 248717835.
- ^ "Bacillus cereus food poisoning associated with fried rice at two child day care centers" (PDF). Morbidity and Mortality Weekly Report. 43 (10). Centers for Disease Control and Prevention. 18 March 1994. Archived (PDF) from the original on 9 October 2022.
- ^ Takabe F, Oya M (March–April 1976). "An autopsy case of food poisoning associated with Bacillus cereus". Forensic Science. 7 (2): 97–101. doi:10.1016/0300-9432(76)90024-8. PMID 823082.
- ^ Mahler H, Pasi A, Kramer JM, Schulte P, Scoging AC, Bär W, Krähenbühl S (April 1997). "Fulminant liver failure in association with the emetic toxin of Bacillus cereus". The New England Journal of Medicine. 336 (16): 1142–1148. doi:10.1056/NEJM199704173361604. PMID 9099658.
- ^ Dierick K, Van Coillie E, Swiecicka I, Meyfroidt G, Devlieger H, Meulemans A, et al. (August 2005). "Fatal family outbreak of Bacillus cereus-associated food poisoning". Journal of Clinical Microbiology. 43 (8): 4277–4279. doi:10.1128/JCM.43.8.4277-4279.2005. PMC 1233987. PMID 16082000.
- ^ Shiota M, Saitou K, Mizumoto H, Matsusaka M, Agata N, Nakayama M, et al. (April 2010). "Rapid detoxification of cereulide in Bacillus cereus food poisoning". Pediatrics. 125 (4): e951 – e955. doi:10.1542/peds.2009-2319. PMID 20194285. S2CID 19744459.
- ^ Naranjo M, Denayer S, Botteldoorn N, Delbrassinne L, Veys J, Waegenaere J, et al. (December 2011). "Sudden death of a young adult associated with Bacillus cereus food poisoning". Journal of Clinical Microbiology. 49 (12): 4379–4381. doi:10.1128/JCM.05129-11. PMC 3232990. PMID 22012017.
- ^ "Medical safety alert: Lipid Phase only of Parenteral Nutrition – potential contamination with Bacillus cereus". UK Medicines and Healthcare products Regulatory Agency. 4 June 2014.
- ^ Cooper C (1 July 2014). "Third baby dies from contaminated 'Total Parenteral Nutrition' drip feed". The Independent. Archived from the original on 18 April 2019.
- ^ Soni A, Oey I, Silcock P, Bremer P (November 2016). "Bacillus Spores in the Food Industry: A Review on Resistance and Response to Novel Inactivation Technologies". Comprehensive Reviews in Food Science and Food Safety. 15 (6): 1139–1148. doi:10.1111/1541-4337.12231. PMID 33401831.
- ^ "Notes from the Field: Contamination of alcohol prep pads with Bacillus cereus group and Bacillus species — Colorado, 2010". Morbidity and Mortality Weekly Report (MMWR). Atlanta, Georgia: Centers for Disease Control and Prevention. 25 March 2011. Archived from the original on 1 July 2018.
- ^ Hsueh PR, Teng LJ, Yang PC, Pan HL, Ho SW, Luh KT (July 1999). "Nosocomial pseudoepidemic caused by Bacillus cereus traced to contaminated ethyl alcohol from a liquor factory". Journal of Clinical Microbiology. 37 (7): 2280–2284. doi:10.1128/JCM.37.7.2280-2284.1999. PMC 85137. PMID 10364598.
- ^ Zhao, Jiayuan; Jiang, Yangdan; Gong, Lanmin; Chen, Xiaofeng; Xie, Qingling; Jin, Yan; Du, Juan; Wang, Shufang; Liu, Gang (15 February 2022). "Mechanism of β-cypermethrin metabolism by Bacillus cereus GW-01". Chemical Engineering Journal. 430: 132961. doi:10.1016/j.cej.2021.132961. ISSN 1385-8947. S2CID 239126417.
- ^ Cheng LW, Rao S, Poudyal S, Wang PC, Chen SC (October 2021). "Genotype and virulence gene analyses of Bacillus cereus group clinical isolates from the Chinese softshell turtle (Pelodiscus sinensis) in Taiwan". Journal of Fish Diseases. 44 (10): 1515–1529. doi:10.1111/jfd.13473. PMID 34125451. S2CID 235426384.
- ^ Gillis A, Mahillon J (July 2014). "Prevalence, genetic diversity, and host range of tectiviruses among members of the Bacillus cereus group". Applied and Environmental Microbiology. 80 (14): 4138–4152. Bibcode:2014ApEnM..80.4138G. doi:10.1128/AEM.00912-14. PMC 4068676. PMID 24795369.
- ^ Kong, Minsuk; Kim, Minsik; Ryu, Sangryeol (June 2012). "Complete Genome Sequence of Bacillus cereus Bacteriophage PBC1". Journal of Virology. 86 (11): 6379–80. doi:10.1128/JVI.00706-12. PMC 3372192. PMID 22570248.
External links
- Bacillus cereus genomes and related information at PATRIC, a Bioinformatics Resource Center funded by NIAID
- Type strain of Bacillus cereus at BacDive – the Bacterial Diversity Metadatabase